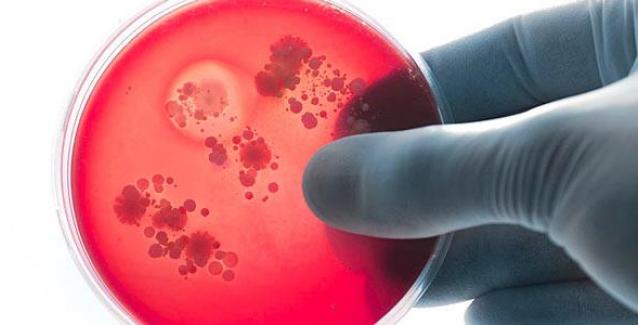

Και δεύτερο περιστατικό μηνιγγίτιδας Β έκανε την εμφάνισή του μέσα στον Ιανουάριο με επίσης αίσια έκβαση καθώς το βρέφος διέφυγε τον κίνδυνο και δεν φαίνεται να υπέστη μόνιμες βλάβες.
Νέο περιστατικό μηνιγγίτιδας καταγράφηκε στις αρχές του έτους στην τοπική κοινωνία της Βέροιας. Αυτή τη φορά ένα αγοράκι 3,5 μηνών, εκδήλωσε υψηλό πυρετό και εισήχθη στο Γενικό Νοσοκομείο Βέροιας όπου υποβλήθηκε στις απαραίτητες εξετάσεις και προληπτικά του χορηγήθηκε φαρμακευτική αγωγή.
Το ίδιο βράδυ το βρέφος εκδήλωσε αιμορραγικό εξάνθημα με αποτέλεσμα να μεταφερθεί και να νοσηλευθεί στο Ιπποκράτειο Νοσοκομείο Θεσσαλονίκης όπου και διαγνώστηκε με μηνιγγίτιδα τύπου Β.
Η άμεση κινητοποίηση του παιδιάτρου της οικογενείας αλλά και των ιατρών στα Νοσοκομεία της Βέροιας και του Ιπποκράτειου, είχε ως αποτέλεσμα το βρέφος να διαφύγει τον κίνδυνο και σήμερα να είναι καλά στην υγεία του.
Στάδια
Υπενθυμίζουμε, ότι η μηνιγγίτιδα Β είναι δύσκολο να διαγνωστεί σε πρώιμο στάδιο καθώς τα αρχικά της συμπτώματα μοιάζουν με αυτά μιας απλής ίωσης. Ωστόσο, η εξέλιξή της μπορεί να είναι ραγδαία και δυνητικά θανατηφόρος, ενώ τα συμπτώματα μπορεί να περιλαμβάνουν υψηλό πυρετό, αυχενική δυσκαμψία, πονοκέφαλο, αιμορραγικό εξάνθημα, έμετο κ.α.